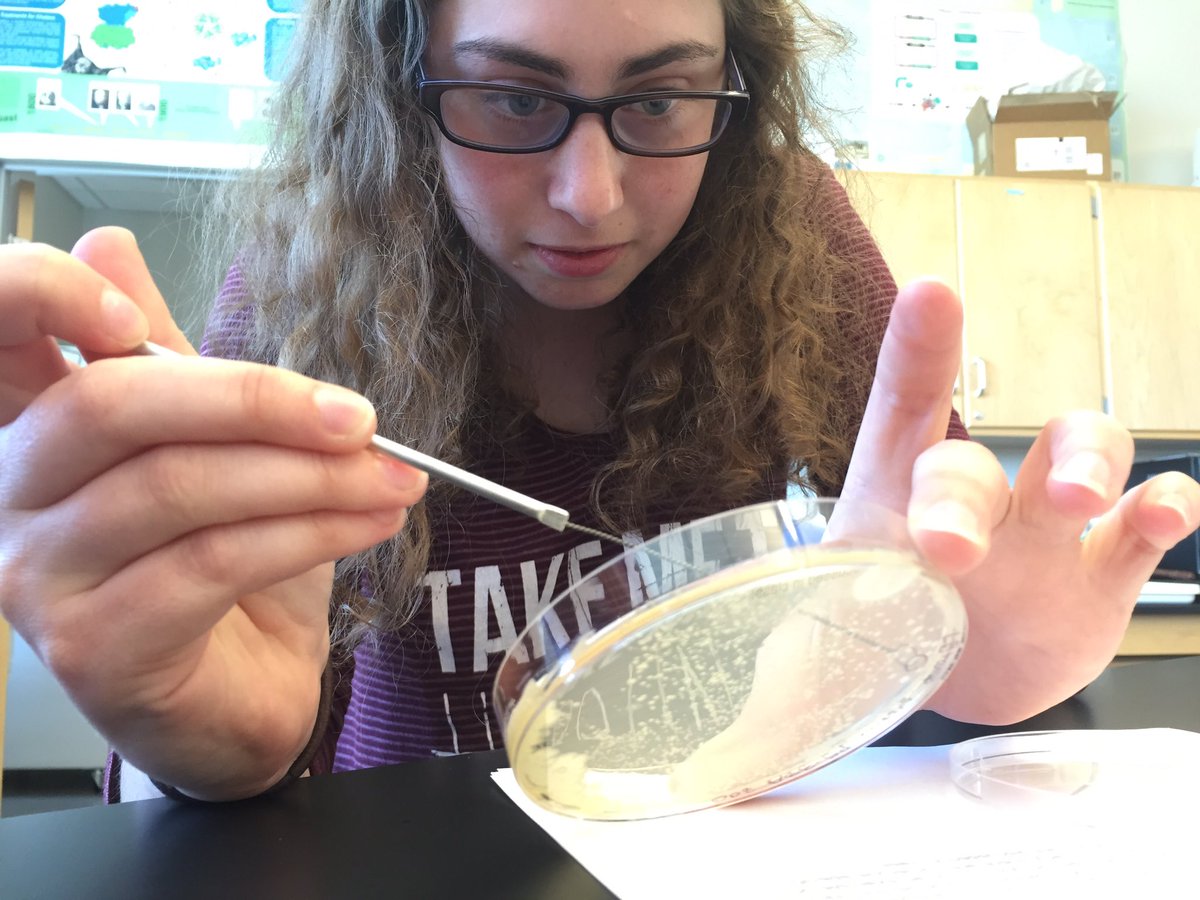
ekesslerkc's tweet image. Attempting to inspire high school biology students has been my #GatewayToScience

#gatewaytoscience Suchergebnisse
My #GatewaytoScience was Gods, Graves and Scholars, especially the story of the ancient attempt to loot Tut's tomb

My #GatewayToScience was growing up collecting insects in Illinois prairies and Wisconsin forests @realscientists

This book right here was a massive #GatewayToScience for me #science #entomology #naturalist books.google.co.uk/books/about/Th…

I honestly got hooked because my HS chemistry textbook was brand new and had beautiful pictures #GatewayToScience

175 individual, inspirational stories who all have different #GatewayToScience #Time4Chem rsc.li/1maqLtV

My #GatewayToScience was the farm I grew up in. Surrounded by nature, I wanted to understand how it worked.

My #GatewayToScience: eye-opening trip to Kenya when I was 16 to volunteer on a #herpetology survey @realscientists

My #GatewayToScience: Beautiful surroundings and a family full of amateur naturalists and biophiles @realscientists

#GatewayToScience - some thoughts on fathers, mothers, Jurassic Park, and PBS protocols.io/groups/protoco…

Outdoors science exhibition #gatewaytoscience @MortonArboretum i wonder who may have designed this part @AndrewLHipp

Our library is positively glowing these days. A great time to make your 1st visit; let us be your #GatewayToScience

We had a great time at the Gateway to Health event at the beautiful new Gateway to Science building this past weekend! #gatewaytoscience #healthfair #familywellnessbisman

Check out this cool design for North Dakotas Gateway to Science in Bismarck! #JustGoPromo #ConsiderItBranded #GatewayToScience #Bismarck #CustomApparel #B2B

Outdoors science exhibition #gatewaytoscience @MortonArboretum i wonder who may have designed this part @AndrewLHipp



Find out why "It's About Much More Than Science." bit.ly/3crBqTj #STEM #STEMeducation #GatewayToScience

Giving Hearts Day is next week, and in this week's blog article we are "Grateful for Giving Hearts." gatewaytoscience.org/2020/02/giving… #GivingHeartsDay #GatewayToScience

"We engage and empower children and families, and spark their passion with hands-on exhibits and programs." Beth Demke, Executive Director gatewaytoscience.org/building #gatewaytoscience #stem #capitalcampaign
Be a part of Gateway to Science's next 25 years. And beyond. gatewaytoscience.org/building #STEM #GatewaytoScience #CapitalCampaign
Thanks to Maggie and Ryan Barth for joining us at Pledge Day last week. The Racetrack exhibit sponsored by @BillBarthFord is a visitor favorite. Want to learn more about the future of Gateway to Science? Visit gatewaytoscience.org/building-proje…. #GatewaytoScience #PledgeWeek #tbt

Oasis Petroleum is generously sponsoring an exhibit on natural gas capture & processing in the new science center. Michael Kukuk joined GTS ED Beth Demke and Honorary Campaign Chair Mikey Hoeven to celebrate the public campaign launch last Thursday #GatewaytoScience #PledgeWeek

Thank you to Mayor Steve Bakken for representing @BismarckNDGov at #GatewaytoScience #PledgeDay yesterday.

Pledge Week continues at @BartlettWest! We are thrilled to announce their lead sponsorship of the Working Water exhibit in our new science center. Thank you for inspiring the scientist in everyone! #GatewaytoScience #PledgeWeek

Aurelia aurita is the easiest jellyfish to keep and breed in captivity. A circular tank, plenty of artemia nauplii & time to be mesmerized by their movement #AquariumHobby #Aquaculture #GatewayToScience
#GatewayToScience #NCSciFest thanks to all who attended, and to our students, faculty and staff. Looking forward to 2020 Event.
How do circuits work? Come out and learn. You still have time event going until 4:30pm #GatewaytoScience #UNCGway #NCAT
Frozen treats with liquid nitrogen! Kids don’t try this at home, but you can try it today at @JSNN2907! #GatewaytoScience #UNCGway #NCAT
My #GatewayToScience was growing up collecting insects in Illinois prairies and Wisconsin forests @realscientists

My #GatewaytoScience was Gods, Graves and Scholars, especially the story of the ancient attempt to loot Tut's tomb

My #GatewayToScience : growing up watching my bro constantly misbehave spurred my fascination with #humanbehaviour
Having a Wild childhood & falling in love with wildlife was my #GatewayToScience - #EveryChildWild @WildlifeTrusts

My #GatewayToScience and me, when I was tiny and when I graduated from the science program in highschool. <3


175 individual, inspirational stories who all have different #GatewayToScience #Time4Chem rsc.li/1maqLtV

On the outside of the door to my lab. Image courtesy of the fabulous @IBJIYONGI committed to be a #GatewayToScience

My #Gatewaytoscience: book my parents bought me, their love of nature & inspiration @WomenSciAUST @realscientists


This book right here was a massive #GatewayToScience for me #science #entomology #naturalist books.google.co.uk/books/about/Th…

My #GatewayToScience: eye-opening trip to Kenya when I was 16 to volunteer on a #herpetology survey @realscientists

Something went wrong.
Something went wrong.
United States Trends
- 1. #twitchrecap 10.8K posts
- 2. Fulham 38.6K posts
- 3. #GivingTuesday 30K posts
- 4. Lewandowski 22.5K posts
- 5. Slay 19K posts
- 6. Larry 56.5K posts
- 7. #TADCFriend N/A
- 8. Olmo 14.6K posts
- 9. Penn State 17K posts
- 10. Pedri 33.5K posts
- 11. Trump Accounts 23.8K posts
- 12. #FULMCI 5,083 posts
- 13. Adam Thielen 2,729 posts
- 14. Foden 21K posts
- 15. Cabinet 90.4K posts
- 16. #AppleMusicReplay 11.4K posts
- 17. Sleepy Don 4,235 posts
- 18. Susan Dell 10.6K posts
- 19. Sabrina Carpenter 38.9K posts
- 20. Zion Williamson N/A